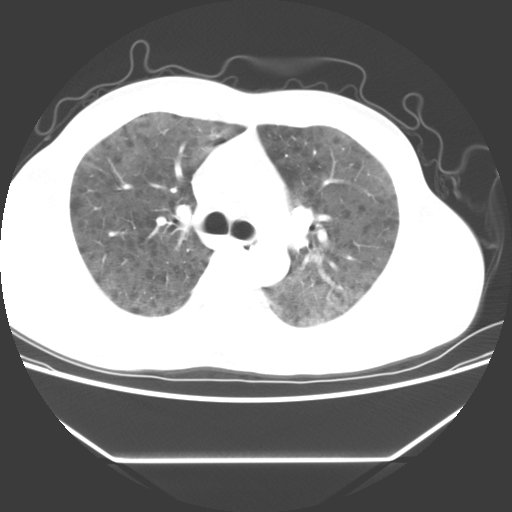

医影在线
标题: CT25380请大家诊断 [打印本页]
作者: wly491109 时间: 2010-3-29 03:09
标题: CT25380请大家诊断
病人55岁,咳嗽,胸闷

[本贴已被 翁志蓬 于 2010-3-28 23:43:40 修改过]
作者: wly491109 时间: 2010-3-29 03:11
忘了传病史了,病人55岁,咳嗽,胸闷
作者: 王显瑞 时间: 2010-3-29 03:56
两肺部呈“毛玻璃”状改变,原因待查考虑感染性病变
作者: 随光逐影 时间: 2010-3-29 04:13
考虑机遇性肺部感染。
作者: jsgdoctor 时间: 2010-3-29 04:16
病人是否发烧,两肺“磨玻璃”影,其间见空气支气管征和碎路石征。考虑肺泡蛋白沉着症。
作者: 好进学子 时间: 2010-3-29 04:19
支持五楼。
病人是否发烧,两肺“磨玻璃”影,其间见空气支气管征和碎路石征。考虑肺泡蛋白沉着症。
作者: 悬壶济世 时间: 2010-3-29 04:28
肺泡蛋白沉着症,支持,病史能不能再详细一点。
作者: mei600 时间: 2010-3-29 04:33
弥漫的病变,肺水肿?
作者: sunbin 时间: 2010-3-29 04:41
两肺广泛对称磨玻璃样影,密度不均,考虑机遇性肺部感染。
作者: 卜一 时间: 2010-3-29 05:07
肺泡蛋白沉着症,支持!!!
作者: 黄毛小子 时间: 2010-3-29 05:19
标题: 回复:请大家诊断
以下是引用卜一在2010-3-28 21:07:00的发言:[br]肺泡蛋白沉着症,支持!!!
作者: frzh 时间: 2010-3-29 05:28
病史提供不详细,肺水肿不能排除,首先考虑肺泡蛋白沉着症
作者: 杨军 时间: 2010-3-29 05:39
双肺弥漫磨玻璃样病变,病史很重要。有感冒或发烧史,甲流不除外。无发烧可考虑肺泡蛋白沉积,但肺泡蛋白沉积边缘往往较清晰,与正常肺组织分界清晰
作者: 联众之王 时间: 2010-3-29 05:45
考虑肺泡蛋白沉着症
作者: 西瓜999号 时间: 2010-3-29 06:40
肺泡蛋白沉着症
作者: 影象小泰斗 时间: 2010-3-29 06:58
两肺弥漫间质性病变,考虑肺泡蛋白沉着症。建议进一步检查。
作者: ze3200636 时间: 2010-3-29 08:54
像肺泡蛋白沉积,建议纤支镜进一步检查。
作者: yangyudong333 时间: 2010-3-29 13:37
病人是否发烧,两肺“磨玻璃”影,其间见空气支气管征和碎路石征。考虑肺泡蛋白沉着症。
作者: yangyudong333 时间: 2010-3-29 13:38
病人是否发烧,两肺“磨玻璃”影,其间见空气支气管征和碎路石征。考虑肺泡蛋白沉着症。
作者: limitian 时间: 2010-3-29 15:10
肺泡蛋白沉着症,支持!
作者: wd8929053 时间: 2010-3-29 17:16
两肺“磨玻璃”影,其间见空气支气管征和碎路石征。考虑肺泡蛋白沉着症。
作者: shibing 时间: 2010-3-29 18:01
肺泡蛋白沉着症,支持,病史能不能再详细一点。
作者: 道哥 时间: 2010-3-29 18:06
病人是否发烧,两肺“磨玻璃”影,其间见空气支气管征和碎路石征。考虑肺泡蛋白沉着症。
作者: muzi888 时间: 2010-3-29 18:41
两肺部呈“毛玻璃”状改变,支持肺泡蛋白沉着症。
作者: 草古木子 时间: 2010-3-29 21:31
肺泡蛋白沉着症。
作者: yuhongjun 时间: 2010-3-29 22:42
标题: 回复
不除外甲流所致的肺部感染或肺泡内出血。[emb12]
[本贴已被 yuhongjun 于 2010-3-29 14:43:11 修改过]
作者: 黑白光影 时间: 2010-3-30 05:34
先考虑感染
作者: wly491109 时间: 2010-4-1 02:24
此病人我并没有见到,病史没有得到更详细,但此病人据说有发低热,请教各位老师,此病人像不像卡氏肺囊虫肺炎
作者: zxl51642 时间: 2010-4-1 03:22
标题: 回复:ct25380请大家诊断
以下是引用随光逐影在2010-3-28 20:13:00的发言:[br]考虑机遇性肺部感染。
考虑pcp?不像肺泡蛋白沉着症。
作者: dr.yang 时间: 2013-5-15 22:09
学习了
| 欢迎光临 医影在线 (http://bbs.radida.com/bbs/) |
Powered by Discuz! X3.2 |